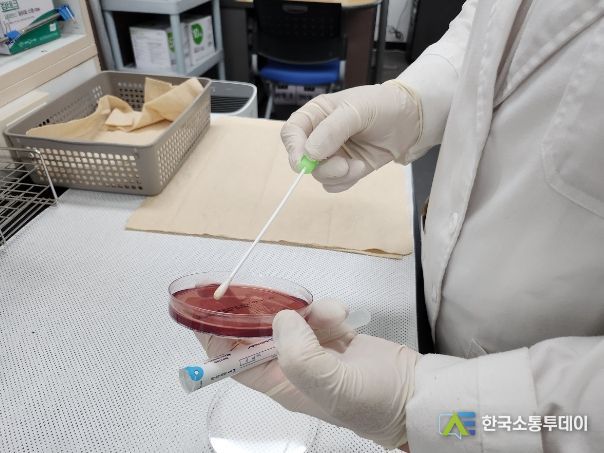

한국소통투데이 관리자 기자 | 파주시는 8월 1일부터 31일까지 집단급식소에서 발생하는 집단식중독에 대비하기 위해 환경가검물 검사를 실시한다.
환경가검물 검사란 칼, 도마, 행주에 가검물(검체) 등을 채취한 다음 임상 배양 실험을 통해 병원성 세균을 검출·확인하는 것이다.
이번 점검은 학교 및 유치원 117곳, 어린이집 91곳, 사회복지시설 24곳, 산업체 등 171곳 등 파주시 관내 집단급식소 403곳을 대상으로 한다.
수거된 가검물은 보건소에서 살모넬라, 대장균 등의 검출 여부를 검사한다. 검사 결과 균이 검출된 업소는 추후 중점 대상업소로 관리할 예정(3개월 이내 다시 점검하여 개선 여부를 확인)이다.
집단급식소의 경우 식중독 발생 시 그 규모가 크고 확산 속도가 빠른 특성 때문에, 이번 환경가검물 검사를 통해 집단급식소 내 식중독 발생을 선제적으로 예방할 수 있을 것으로 기대하고 있다.
이이구 위생과장은 “파주시는 안전한 급식환경을 조성하기 위해 매년 집단급식소 환경가검물 전수 검사를 실시하고 있다”라며 “앞으로도 급식시설에 대한 안전관리를 강화하고 식중독 예방 교육을 지속적으로 실시해 안전한 식생활 환경을 조성하기 위해 최선을 다하겠다”라고 말했다.
